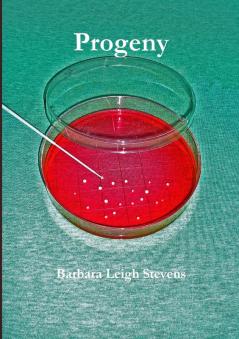
Progeny

English
Paperback
₹2548
₹2657
4.1% OFF
(All inclusive*)
Delivery Options
Please enter pincode to check delivery time.
*COD & Shipping Charges may apply on certain items.
Review final details at checkout.
Looking to place a bulk order? SUBMIT DETAILS
About The Book
Description
Author
A young groom does not arrive at the church for his wedding but the loyal bride is adamant that she has not been stood up. It is only a few hours later that a glider enthusiast gazes out his plane window and then calls the police to report seeing a body lying in a remote farm pasture. Sympathy floods in for the poor devastated bride. Everyone who knew them thought they had made the perfect-perhaps too perfect. Within days the city is rocked again by the murder of a prominent physician. This time though the killing does not occur in the isolated environs of the rural countryside but amidst throngs of people gathered for the popular annual Soupfest in the core of the city. Detective Sergeant Timothy Earley and his team of investigators are led through a myriad of confusing dead-ended scenarios until they begin to realize that the two murders are connected. The link lies beyond their wildest imaginings and hides a scam that has the potential to devastate the lives of many families within the region.
Delivery Options
Please enter pincode to check delivery time.
*COD & Shipping Charges may apply on certain items.
Review final details at checkout.
Details
ISBN 13
9781300073819
Publication Date
-10-08-2012
Pages
-442
Weight
-532 grams
Dimensions
-148x210x22.77 mm